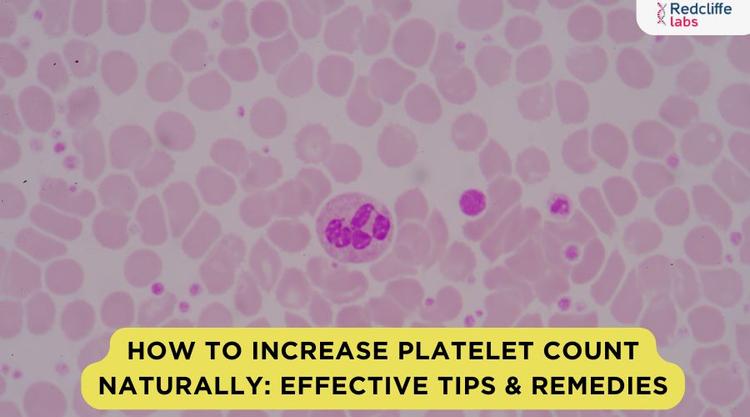
How to Increase Platelet Count Naturally: Effective Tips & Remedies
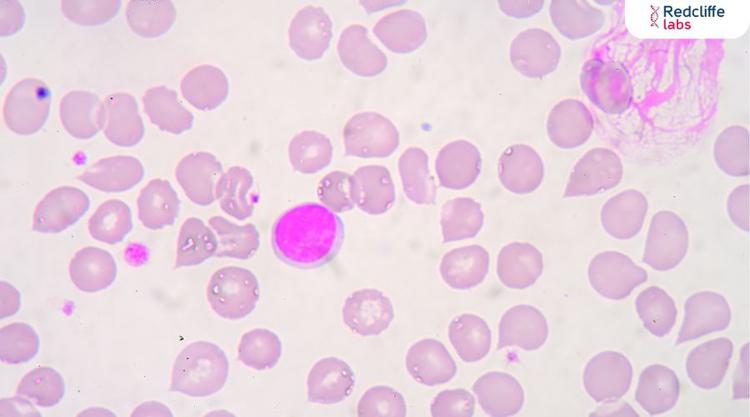
Lymphocytes in Hindi: प्रकार, कार्य और स्वास्थ्य के लिए महत्व
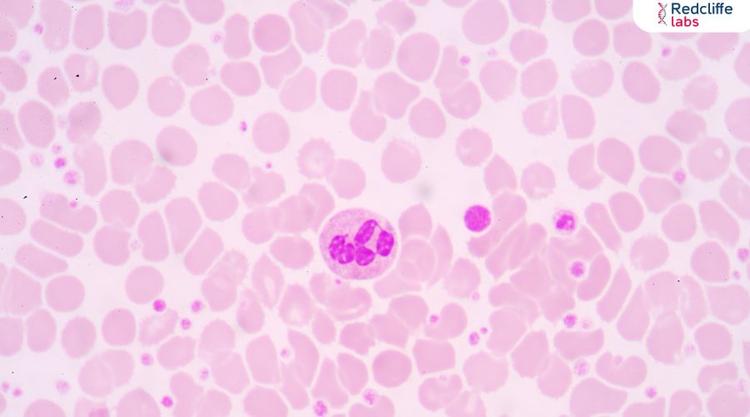
Platelets Meaning in Marathi: काय आहेत आणि त्यांचे कार्य काय आहे?

Blood

Reasons for Low Hemoglobin: Common Causes and How to Fix Them

Ways to Increase Platelet Counts in Blood Naturally

Red Blood Cells (RBCs): Functions, Role, and Importance

Blood Genotype Test: All You Need to Know

रक्त वाढीसाठी काय खावे (What to Eat to Increase Blood)

हिमोग्लोबिन कमी होण्याची कारणे आणि त्यासंबंधी संपूर्ण माहिती

हीमोग्लोबिन कैसे बढ़ाएं? जानें क्या खाएं और घरेलू उपाय
How to Increase Platelet Count Naturally: Effective Tips & Remedies

The Blood Type Diet: Eat the Right for Your Type

प्लेटलेट्स बढ़ाने वाले फल: कारण, लाभ और संपूर्ण जानकारी

Golden Blood: Its type, Benefits, and More

Hemoglobin Meaning in Hindi: हीमोग्लोबिन का अर्थ और इसकी पूरी जानकारी

Who is a True Universal Donor? Know About All Blood Types

How to Increase Your Hemoglobin? 8 Proven Ways

What Does MCH Low Means in Blood Test Results?

How to Increase RBC Count Naturally?

Top Blood Donation Benefits: Save Lives & Improve Your Health

Anemia Meaning in Marathi: कारणे, लक्षणे आणि उपचार
Lymphocytes in Hindi: प्रकार, कार्य और स्वास्थ्य के लिए महत्व
Platelets Meaning in Marathi: काय आहेत आणि त्यांचे कार्य काय आहे?


